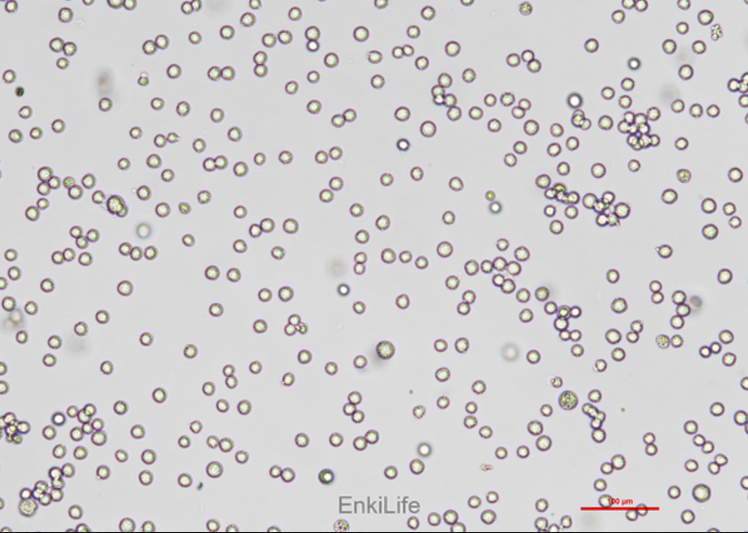

1YR企业会员
发布人:武汉恩玑生命科技有限公司
发布日期:2025/7/18 14:22:13
人骨髓增生异常综合征(MDS)细胞系SKM-1是一种广泛用于研究MDS及其相关治疗策略的细胞模型。SKM-1细胞系来源于日本研究生物资源细胞库,具有多种生物学特性,使其成为研究MDS的理想工具[3]。
SKM-1细胞系表现出显著的增殖抑制特性,这在多项研究中得到了验证。例如,黄芩苷(wogonin)和褐藻多糖(fucoidan)均能显著抑制SKM-1细胞的增殖,并诱导细胞凋亡[3,4]。这些化合物通过不同的机制发挥作用,如黄芩苷主要通过诱导细胞周期停滞来抑制增殖,而fucoidan则通过激活凋亡途径和产生活性氧(ROS)来抑制增殖[3,4]。
此外,SKM-1细胞系还被用于研究药物耐药性。例如,耐高三尖杉酯碱的SKM-1细胞系已被建立,并用于探讨多药耐药机制[2]。此外,SKM-1细胞系还被用于研究基因沉默和药物联合治疗的效果。例如,通过沉默SPAG6基因并使用地西他滨处理SKM-1细胞,可以观察到细胞凋亡和PTEN去甲基化的作用[7]。
在基因型和表型特征方面,SKM-1细胞系也表现出一定的异质性。例如,甲氨蝶呤敏感和耐药的SKM-1细胞系(SKM1-S和SKM1-R)在形态学上存在差异,但它们在基因型上具有相似性,这表明尽管存在形态上的变化,但基因突变模式保持一致[5]。
总之,SKM-1细胞系因其在MDS研究中的广泛应用和显著的生物学特性,成为研究MDS发病机制、药物筛选及耐药性研究的重要工具。
SKM-1细胞系在人骨髓增生异常综合征研究中的具体应用是什么?
SKM-1细胞系在人骨髓增生异常综合征(MDS)研究中的具体应用主要体现在以下几个方面:

黄芩苷和褐藻多糖如何具体影响SKM-1细胞的增殖和凋亡?
黄芩苷和褐藻多糖对SKM-1细胞的增殖和凋亡影响具体如下:
黄芩苷(wogonin)在时间和剂量依赖性方式下抑制了SKM-1细胞的增殖。通过荧光显微镜观察,未处理的SKM-1细胞呈现淡蓝色荧光,而受wogonin处理的细胞显示出剂量相关的凋亡细胞比例增加,表现为更深的蓝色荧光,表明细胞发生了凋亡[3]。进一步的Annexin V/PI双染色实验显示,wogonin在SKM-1细胞中诱导了剂量依赖性的凋亡,且随着实验时间的延长,凋亡率显著增加。这表明wogonin处理导致SKM-1细胞进入G0/G1期,细胞周期蛋白表达水平发生变化,如CDK4和cyclin D1的表达减少,而p21Cip1和p27Kip1的表达增加,表明细胞周期停滞在G1/S期转换点,从而抑制细胞生长[3]。此外,wogonin处理还上调了与凋亡相关的蛋白Bax、激活的caspases 3和9以及c-PARP的表达,同时下调了抗凋亡蛋白Bcl-2的表达,进一步证实了其诱导细胞凋亡的作用[3]。
褐藻多糖(fucoidan)通过激活外源性和内源性凋亡途径,诱导SKM-1细胞凋亡。研究发现,fucoidan能增加Fas的表达,激活外源性凋亡途径,进而促进细胞凋亡[4]。此外,fucoidan还能抑制PI3K/Akt信号通路,通过激活caspase-9,进一步增强凋亡信号[4]。fucoidan还能增加细胞内ROS水平,导致细胞周期停滞和凋亡[4]。流式细胞术分析显示,fucoidan处理后,SKM-1细胞的凋亡率从16.4%显著增加到28.2%[4]。细胞周期分析显示,fucoidan处理组中G1/G0期细胞比例显著增加,而S期和G2/M期细胞比例显著减少[4]。聚合酶链反应和Western blot分析表明,fucoidan处理后,Fas、caspase-3、caspase-8和caspase-9的mRNA表达水平分别提高了0.5-3倍[4]。此外,fucoidan还抑制了PI3K/Akt信号通路,导致磷酸化Akt蛋白表达下降[4]。
黄芩苷和褐藻多糖均通过不同的机制抑制SKM-1细胞的增殖并诱导其凋亡。
SKM-1细胞系耐高三尖杉酯碱的机制是什么?
SKM-1细胞系耐高三尖杉酯碱的机制并未直接提及。然而,[19]中提到SKM-1细胞对地西他滨(DAC)的耐药性可能与hENT1基因的低表达有关[3]。这表明SKM-1细胞系可能通过降低hENT1的表达来抵抗某些药物,尽管具体到高三尖杉酯碱的耐药机制并未明确说明。
SPAG6基因沉默对SKM-1细胞凋亡和PTEN去甲基化的影响如何?
SPAG6基因沉默对SKM-1细胞凋亡和PTEN去甲基化的影响主要体现在以下几个方面:
SPAG6基因沉默通过多种机制诱导SKM-1细胞凋亡,并可能通过影响PTEN的甲基化状态来进一步促进凋亡。
SKM1-S和SKM1-R细胞系在形态学和基因型上的差异及其对治疗反应的影响是什么?
SKM1-S和SKM1-R细胞系在形态学和基因型上的差异及其对治疗反应的影响主要体现在以下几个方面:
SKM1-S和SKM1-R细胞系在形态学和基因型上的差异显著,并且这些差异影响了它们对治疗药物AZA的反应。
参考文献:
1. MEK/ERK and PI3K/AKT pathway inhibitors affect the transformation of myelodysplastic syndrome into acute myeloid leukemia via H3K27me3 methylases and de‑methylases. [PMID: 37921060]
2. 耐高三尖杉酯碱人SKM-1细胞系的建立及其生物学特性观察 [J] . 中华血液学杂志,2012,33( 06 ): 433-438.
3. Wogonin inhibits the proliferation of myelodysplastic syndrome cells through the induction of cell cycle arrest and apoptosis. [PMID: 26398525]
4. Fucoidan inhibits proliferation of the SKM-1 acute myeloid leukaemia cell line via the activation of apoptotic pathways and production of reactive oxygen species. [PMID: 26324225]
5. Phenotypic and genotypic characterization of azacitidine-sensitive and resistant SKM1 myeloid cell lines. [PMID: 24962689]
6. WEE1 and PARP-1 play critical roles in myelodysplastic syndrome and acute myeloid leukemia treatment. [PMID: 37370065]
7. SPAG6基因沉默和地西他滨对SKM-1细胞凋亡和PTEN甲基化的影响 [J] . 中华血液学杂志, 2021, 42(12) : 1005-1010.
8. Methylation level of Rap1GAP and the clinical significance in MDS. [ PMID: 30546468]
9. 骨髓增生异常综合征发病机制及预后研究进展 [J] . 白血病·淋巴瘤, 2019, 28(3) : 129-131.
10. BIIB021对MDS细胞株Skm-1增殖的多靶点抑制作用研究. [作者:李静 · 2017]
11. Bmi-1基因及其编码蛋白在SKM-1细胞系中的表达[J]. 肿瘤防治研究, 2006, 31(02): 83-85.
12. 骨髓增生异常综合征zuixin研究进展 [J] . 白血病·淋巴瘤, 2016, 25(7) : 441-444. DOI: 10.
13. Functional study of hENT1 on SKM-1 cell resistance to decitabine. [PMID: 26031529]
14. Glutathione promotes the synergistic effects of venetoclax and azacytidine against myelodysplastic syndrome‑refractory anemia by regulating the cell cycle. [PMID: 38023359]
15. Effect of Artesunate on Proliferation, Cell Cycle and Apoptosis of SKM-1 Cells and Its Underlying Mechanisms. [PMID: 26913409]
16. miR-378 inhibits cell growth and enhances apoptosis in human myelodysplastic syndromes.[ PMID: 27633496]
17. 青蒿琥酯对高危MDS细胞株SKM-1中DNMT1表达的影响[J]. 河北医科大学学报
18. Fucoidan inhibits proliferation of the SKM-1 acute myeloid leukaemia cell line via the activation of apoptotic pathways and production of reactive oxygen species. [PMID: 26324225]
19. SKM-1细胞地西他滨耐药机制中hENT1功能的研究 [J] . 中华血液学杂志, 2015, 36(5) : 408-412.
20. Effects of SPAG6 silencing and decitabine treatment on apoptosis and phosphatase and tensin homolog methylation in SKM-1 cells. [PMID: 35045671]
21. SPAG6 silencing induces autophagic cell death in SKM-1 cells via the AMPK/mTOR/ULK1 signaling pathway. [PMID: 32537026]
22. MiR-143 regulates proliferation and apoptosis of SKM-1 cells in vitro by inhibiting AF9 [J]. Journal of Third Military Medical University, 2018, 40(20): 1826-1832. [PMID: 30132510]
相关新闻资讯